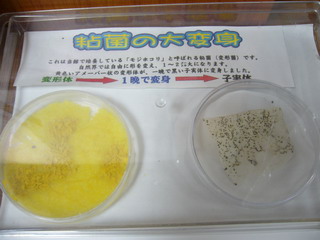

ただのにっき
書きなぐり
初聖地の旅ラスト。
本日もサイコーの天気。

聖地が聖地たる由縁なところへ行くので、もードッキドキ。
ホテルをチェックアウトして、朝っぱらから向かった先はココ。

ハトち○こウルトラナビのおかげで、迷うことなく到着してしまった。
否が応にもテンションはMAXに。
あああああーーー。

ネ申が親に建ててあげた、ネ申のご両親とお手伝いさんが住む豪邸です。
盆暮には親子3人で帰ってくる豪邸です。
モッキンが「ピンポンダッシュしよー!」とか
「ストーカーー♪」とか歌っててうるさいが、ほっといて
”生んでくれてありがとう”と念じました。
特に要塞ってわけでもないんだけど、不思議な造りで
横からはこの道を登って行くみたい。

連休ののんびりしたブランチタイムの閑静な住宅街に
異様なテンションで乗り込んだけど、撮影して速攻立ち去ったのでした。
だって、心臓飛び出るもん。
オレさまの小心さは、ネ申を目の前にした数回の挙動によって
既に知る人ぞ知るところだが、ネ申の聖地に足を踏み入れる今回の旅も
迷いに迷った挙句、マヨとの2ショット写真を見た際に
やっとこ決意出来たのであった。
問題の決意画像はこちら。

何故かコレを見た瞬間「そうだ、聖地へ行こう」と思えたのですよ。
うまく説明出来ないけど、妄信的レベルが1コ下がったみたいな感じ。
とっととメッカを後にし、鼓動の高鳴りがおさまらないまま
近くのエバグリで要らない買い物。入浴剤とかww

和歌山駅に戻る間、ハトち○こスーパーナビ@運動会中により
アプル跡地らしきところを発見。

海も山も街もあるところで、名曲を紡ぐ才能を育んでいたのだね。
感動してる間もなく、紀州徳川家の居城に到着。

和歌山名産の青石が敷き詰められたかなり険しい坂を登る。

天守閣からは紀ノ川が一望。

天守閣内のライトがかわいー。

松がかわいー。

駐車場には何故かけいおん痛車が。

とんでもなく腹が減ったので、何もない和歌山駅に向かってみましょう。

ほんとにココは駅前ですか?っつぅくらい何もないゾ。
しょうがないから、小鯛雀鮨で有名な水了軒がやってるらしきうどん屋へ。

鯛寿司と鯖寿司。おいしー。

うどんはフツー。

そいから、ネ申がバイトしてた店舗ではないけど、やはりお約束のようにココへ。

何年かぶりにポンデリングを食べたなり。

車の中からも思ってたけど、どこのミスドも大行列で
和歌山では休日にドーナツ食うのが大流行中なのか?と思ってたら
全品100円セール中だったのね。ぐっさんの歌か。
自分なりのネ申ルートを満喫したことを指差し確認し
聖地を後にして関空へ向かう。

帰りは大好きスタフラに乗りたいので、株優で。
行きが予想外だったので、かなりの痛手だが致し方ない。
時間が大いにあるので、たこ昌でタコヤキビールと

明石焼き。

羽田と違って関空はB級グルメ屋さんがいっぱい入ってて楽しい。
モク部屋にちゃんと椅子もあって、キレイ。

かこいーな。

機内の安全ビデオがニンジャですんごい面白かった。
こゆセンス、すごいスキだなー。
ぜんまいザムライをやってたので、堪能。

もちろんタリーズコーヒー&チョコをいただきます。

帰りのリムジンで東京タワーが青かった。

あー帰ってきちゃった。
やっぱ和歌山は千葉に似ている。
もともと和歌山の人が千葉に醤油を伝えたんだから、逆だけども。
聖地ネ申巡りも出来たので、惑星エレーニンが来ても
思い残すことはありません。
聖地が聖地たる由縁なところへ行くので、もードッキドキ。
ホテルをチェックアウトして、朝っぱらから向かった先はココ。
ハトち○こウルトラナビのおかげで、迷うことなく到着してしまった。
否が応にもテンションはMAXに。
あああああーーー。
ネ申が親に建ててあげた、ネ申のご両親とお手伝いさんが住む豪邸です。
盆暮には親子3人で帰ってくる豪邸です。
モッキンが「ピンポンダッシュしよー!」とか
「ストーカーー♪」とか歌っててうるさいが、ほっといて
”生んでくれてありがとう”と念じました。
特に要塞ってわけでもないんだけど、不思議な造りで
横からはこの道を登って行くみたい。
連休ののんびりしたブランチタイムの閑静な住宅街に
異様なテンションで乗り込んだけど、撮影して速攻立ち去ったのでした。
だって、心臓飛び出るもん。
オレさまの小心さは、ネ申を目の前にした数回の挙動によって
既に知る人ぞ知るところだが、ネ申の聖地に足を踏み入れる今回の旅も
迷いに迷った挙句、マヨとの2ショット写真を見た際に
やっとこ決意出来たのであった。
問題の決意画像はこちら。
何故かコレを見た瞬間「そうだ、聖地へ行こう」と思えたのですよ。
うまく説明出来ないけど、妄信的レベルが1コ下がったみたいな感じ。
とっととメッカを後にし、鼓動の高鳴りがおさまらないまま
近くのエバグリで要らない買い物。入浴剤とかww
和歌山駅に戻る間、ハトち○こスーパーナビ@運動会中により
アプル跡地らしきところを発見。
海も山も街もあるところで、名曲を紡ぐ才能を育んでいたのだね。
感動してる間もなく、紀州徳川家の居城に到着。
和歌山名産の青石が敷き詰められたかなり険しい坂を登る。
天守閣からは紀ノ川が一望。
天守閣内のライトがかわいー。
松がかわいー。
駐車場には何故かけいおん痛車が。
とんでもなく腹が減ったので、何もない和歌山駅に向かってみましょう。
ほんとにココは駅前ですか?っつぅくらい何もないゾ。
しょうがないから、小鯛雀鮨で有名な水了軒がやってるらしきうどん屋へ。
鯛寿司と鯖寿司。おいしー。
うどんはフツー。
そいから、ネ申がバイトしてた店舗ではないけど、やはりお約束のようにココへ。
何年かぶりにポンデリングを食べたなり。
車の中からも思ってたけど、どこのミスドも大行列で
和歌山では休日にドーナツ食うのが大流行中なのか?と思ってたら
全品100円セール中だったのね。ぐっさんの歌か。
自分なりのネ申ルートを満喫したことを指差し確認し
聖地を後にして関空へ向かう。
帰りは大好きスタフラに乗りたいので、株優で。
行きが予想外だったので、かなりの痛手だが致し方ない。
時間が大いにあるので、たこ昌でタコヤキビールと
明石焼き。
羽田と違って関空はB級グルメ屋さんがいっぱい入ってて楽しい。
モク部屋にちゃんと椅子もあって、キレイ。
かこいーな。
機内の安全ビデオがニンジャですんごい面白かった。
こゆセンス、すごいスキだなー。
ぜんまいザムライをやってたので、堪能。
もちろんタリーズコーヒー&チョコをいただきます。
帰りのリムジンで東京タワーが青かった。
あー帰ってきちゃった。
やっぱ和歌山は千葉に似ている。
もともと和歌山の人が千葉に醤油を伝えたんだから、逆だけども。
聖地ネ申巡りも出来たので、惑星エレーニンが来ても
思い残すことはありません。
PR
初聖地の旅その2。
今日もイイ天気ーてか、焼けそうな日差し。

海を見ながらバイキング朝ご飯。

このバイキングで、要介護モッキンが味噌汁をド派手にこぼし
Tシャツとパンツを味噌まみれにしやがったので
早めにチェックアウトする予定がもろくも崩れ去り
洗濯という余計な時間を過ごすこととなる。バヤ!
何とかパンツも乾いて、やっと来れましたアドベンチャーワールド。

エンドランスが、ねずみーランドに少し似ています。

こんな水飲み場があちこちに。

サファリを回るケニア号乗り場のまん前で、キツネザルがイチャイチャしてた。

わーライオンー!

ヒグマカラスー!

そして何故か、肉食動物エリアにサルー!

小1時間、ケニア号でサファリを巡ってから、メインの大熊猫!

ニヤリと笑ってないかいコイツ。
連休だとゆーのに、人少なくて見放題だったんだけども


オッサンみたいだった。
コイツなんか、人が入ってるみたいじゃない?やってらんねーみたいだし。

炎天下の中、外にも1頭。歩く姿はまんまクマだな。

上野で行列並ぶのがアホらしいほど、パンダらけ。
せっかくだから観覧車乗る。

すぐ横が南紀白浜空港と滑走路。

ふれあい広場でプレーリードッグとふれあいたいが、孤高過ぎて無理。

数字の2。

オッサンと。

と、何やら音楽隊の音が聞こえてきて・・・ええええー!
極悪顔の大熊猫パレード!!

ポニーとかヤギとかパレード!

リスザルとか肩に乗っけてパレード・・・

笑い殺されるかとオモタ。油断は禁物だぜ。
気を取り直してペンギン村へ。

半目を撮ろうと近寄ってズームしたら、目つぶりやがった。

空飛ぶペンギンもいるんです。

換羽中のキングペンギンの赤ちゃん。キウイみたい。

パンダだけ見てさっさと後にするはずが
ゆるさ加減が面白くって、かなり時間を費やしてしまった。
ココで働きたーい。
さて、それから円月島を横目に

今回の旅2番手の目的である南方熊楠記念館へ。

仲良しだった孫文らと写ってる写真。

那智の粘菌。

コレ見たかったんだー粘菌をマッチ箱に保存してたっての。

粘菌は動物で生まれて植物に変化するのです。
熊楠が天皇に熱く語った、尻尾にエボシ貝を寄生させた海蛇。

「鶏」に関する腹稿。キティガイすぐる。

ハドリアヌスダケ。ち○こにそっくりなので興味津々だったよーだ。

太平洋戦争の足音が忍び寄る頃、75歳で永眠。

弟に金を無心し続け、外国行きまくって好き勝手なことやってきて
それでも長男の発狂だの、県との対立だの色んなことに苦労して
盛りだくさんな豪快人生だ。
ほぼ一生を全裸で過ごして、かぶれた金玉が何年も腫れ上がったとか
好きなタイミングで嘔吐出来る技とか、偉人ぽくないことはやはり隠されてはいたが
こんな変人に「会ってみたい」と駄々こねた昭和天皇って、意外にスゴイと思う。
屋上から神島を眺めて、そう思う。

帰り際、本を2冊買った。
「慶応3年生まれ 7人の旋毛曲がり」と「縛られた巨人-南方熊楠の生涯-」。
この記念館でとっても残念だったのは
先にいた大阪弁の家族のガキが、館内をキャーキャー走り回ってて
それを親が注意しないどころか、一緒になって走り回ってたこと。
資料館とか好きで、旅に行くと必ずご当地資料館に行くけど
こんな現場、初めてだ。ワナワナするほどうるさかった。
こういう時こそ、静かにしなくちゃいけない場所として
教えるいい機会なのでは?と思うのは、子持ちでないから思うのか?
何か熊楠を陵辱されてる気分だった。
神経疑っちゃう。
それから山を下りて、ココで

円月島の穴が見えない角度で

伊勢海老ランチ!何故ランチ!

身の厚さをお知らせしたいが、よく分からんと思う。

プリップリに美味しくて、腹がはち切れた。
そいから、とれとれ市場に寄って

夕日を追っかけて、和歌山市内へ。

複雑な裏道に化かされ、やっとたどり着いたビッグ愛。

この県民交流プラザの上のフロアが格安ホテルになっとるとです。

昨日の宿とは段チな狭さ、あんどアメニティのなさだが、致し方あるまい。
ひとまず腹減ったので、タクシー呼んで
運転手さんに「飲み屋あるとこまで連れてって」と言ってみたのだが
悩んだ挙句連れてってくれたのは、和歌山城近辺のワタミ・・・。
なんかさ、和歌山って繁華街ってものがないっぽ。
ぽつんぽつんとチェーン店が並んでるくらい。
たまにヨサゲな店を見つけると満員だったりする。
しかも風が冷たくなってきて、寒い。
ウロウロしまくって、何とか入れそうな店を見つけた。

ココがね、苦肉の策とはいえ大ヒットだった。
イベリコ豚のカルパッチョ。ナマでうまいー!

イベリコスライサーが圧巻です。

イベリコ豚のはりはり鍋も食べちゃお。

いや~コレが、甘味があって柔らかくてすんごかったの!

追加もして、シメはラーメンで。

飛び込みだったのに、本とに美味しかった。
あー余は満足ぢゃーと、タクシーにコンビニ寄ってもらいつつ帰り
部屋飲みしながら、探偵ナイトスクープを堪能。

今日はいろんな勉強をしたし、感化されたなーむにゃむにゃ。
海を見ながらバイキング朝ご飯。
このバイキングで、要介護モッキンが味噌汁をド派手にこぼし
Tシャツとパンツを味噌まみれにしやがったので
早めにチェックアウトする予定がもろくも崩れ去り
洗濯という余計な時間を過ごすこととなる。バヤ!
何とかパンツも乾いて、やっと来れましたアドベンチャーワールド。
エンドランスが、ねずみーランドに少し似ています。
こんな水飲み場があちこちに。
サファリを回るケニア号乗り場のまん前で、キツネザルがイチャイチャしてた。
わーライオンー!
ヒグマカラスー!
そして何故か、肉食動物エリアにサルー!
小1時間、ケニア号でサファリを巡ってから、メインの大熊猫!
ニヤリと笑ってないかいコイツ。
連休だとゆーのに、人少なくて見放題だったんだけども
オッサンみたいだった。
コイツなんか、人が入ってるみたいじゃない?やってらんねーみたいだし。
炎天下の中、外にも1頭。歩く姿はまんまクマだな。
上野で行列並ぶのがアホらしいほど、パンダらけ。
せっかくだから観覧車乗る。
すぐ横が南紀白浜空港と滑走路。
ふれあい広場でプレーリードッグとふれあいたいが、孤高過ぎて無理。
数字の2。
オッサンと。
と、何やら音楽隊の音が聞こえてきて・・・ええええー!
極悪顔の大熊猫パレード!!
ポニーとかヤギとかパレード!
リスザルとか肩に乗っけてパレード・・・
笑い殺されるかとオモタ。油断は禁物だぜ。
気を取り直してペンギン村へ。
半目を撮ろうと近寄ってズームしたら、目つぶりやがった。
空飛ぶペンギンもいるんです。
換羽中のキングペンギンの赤ちゃん。キウイみたい。
パンダだけ見てさっさと後にするはずが
ゆるさ加減が面白くって、かなり時間を費やしてしまった。
ココで働きたーい。
さて、それから円月島を横目に
今回の旅2番手の目的である南方熊楠記念館へ。
仲良しだった孫文らと写ってる写真。
那智の粘菌。
コレ見たかったんだー粘菌をマッチ箱に保存してたっての。
粘菌は動物で生まれて植物に変化するのです。
熊楠が天皇に熱く語った、尻尾にエボシ貝を寄生させた海蛇。
「鶏」に関する腹稿。キティガイすぐる。
ハドリアヌスダケ。ち○こにそっくりなので興味津々だったよーだ。
太平洋戦争の足音が忍び寄る頃、75歳で永眠。
弟に金を無心し続け、外国行きまくって好き勝手なことやってきて
それでも長男の発狂だの、県との対立だの色んなことに苦労して
盛りだくさんな豪快人生だ。
ほぼ一生を全裸で過ごして、かぶれた金玉が何年も腫れ上がったとか
好きなタイミングで嘔吐出来る技とか、偉人ぽくないことはやはり隠されてはいたが
こんな変人に「会ってみたい」と駄々こねた昭和天皇って、意外にスゴイと思う。
屋上から神島を眺めて、そう思う。
帰り際、本を2冊買った。
「慶応3年生まれ 7人の旋毛曲がり」と「縛られた巨人-南方熊楠の生涯-」。
この記念館でとっても残念だったのは
先にいた大阪弁の家族のガキが、館内をキャーキャー走り回ってて
それを親が注意しないどころか、一緒になって走り回ってたこと。
資料館とか好きで、旅に行くと必ずご当地資料館に行くけど
こんな現場、初めてだ。ワナワナするほどうるさかった。
こういう時こそ、静かにしなくちゃいけない場所として
教えるいい機会なのでは?と思うのは、子持ちでないから思うのか?
何か熊楠を陵辱されてる気分だった。
神経疑っちゃう。
それから山を下りて、ココで
円月島の穴が見えない角度で
伊勢海老ランチ!何故ランチ!
身の厚さをお知らせしたいが、よく分からんと思う。
プリップリに美味しくて、腹がはち切れた。
そいから、とれとれ市場に寄って
夕日を追っかけて、和歌山市内へ。
複雑な裏道に化かされ、やっとたどり着いたビッグ愛。
この県民交流プラザの上のフロアが格安ホテルになっとるとです。
昨日の宿とは段チな狭さ、あんどアメニティのなさだが、致し方あるまい。
ひとまず腹減ったので、タクシー呼んで
運転手さんに「飲み屋あるとこまで連れてって」と言ってみたのだが
悩んだ挙句連れてってくれたのは、和歌山城近辺のワタミ・・・。
なんかさ、和歌山って繁華街ってものがないっぽ。
ぽつんぽつんとチェーン店が並んでるくらい。
たまにヨサゲな店を見つけると満員だったりする。
しかも風が冷たくなってきて、寒い。
ウロウロしまくって、何とか入れそうな店を見つけた。
ココがね、苦肉の策とはいえ大ヒットだった。
イベリコ豚のカルパッチョ。ナマでうまいー!
イベリコスライサーが圧巻です。
イベリコ豚のはりはり鍋も食べちゃお。
いや~コレが、甘味があって柔らかくてすんごかったの!
追加もして、シメはラーメンで。
飛び込みだったのに、本とに美味しかった。
あー余は満足ぢゃーと、タクシーにコンビニ寄ってもらいつつ帰り
部屋飲みしながら、探偵ナイトスクープを堪能。
今日はいろんな勉強をしたし、感化されたなーむにゃむにゃ。
初聖地の旅その1。
やつぱり・・・。
昨日の台風で午後の羽田発着便がほとんど欠航になったため
今日の便は余裕のヨシオだったはずなのに、全便満席に。
とりあえず昨日のうちに念のため特割で買っといてよかったが
余計な出費だ。今は考えないでおこう。
機材繰りの影響もあり、遅延で20分ほど待たされたところで
いきなりのバスラウンジへ搭乗口変更。
エンジンオイルが漏れてたらしく、機材も変更。
はーーー。とぼとぼ歩いてバスラウンジへ行き

「搭乗券で1000円分の買い物が出来まーす」というので
殺到した売店に並び、「ことりっぷ」をタダ買い。
結局1時間ほど遅れて出発。
初の関空に降り立った。

伊勢丹紙袋みたいな服を着てるお笑いの人に激似な、腰低過ぎな人と
舌が短すぎて何しゃべってるのか不明なおっさんがいるレンタカー屋で車を借り
いざ、聖地紀州へ。

東京は台風一過で蒸し暑かったけど、こっちは涼しい。
1時間半ほどで、白浜は三段壁へ。

和歌山出身の香里奈似の歯医者受付のおねいちゃんイチオシの
観光スポットならぬ自殺スポットだ。
海の色がミドリー!

中国訛りのおねいちゃんが案内するエレベーターで
地下36mの海蝕洞窟の内部に降り立つ。

熊野水軍が船を隠していたというこの洞窟で見れたザッパーーン!

干潮だとこんな迫力はないんだろう。
いつも干潮で鳥居のとこまで歩けてしまう宮島しか見たことないオレさまにとっては
今日は幸運であった。
ココから船で出撃してたのかー。

似合っちゃうなー水軍が。

そいへば、洞窟内で1枚だけ大量のオーブが撮れた。

もちろんこの前後も同じアングルなのに、クリアに撮れてる。
後から、この辺でモッキンが人の気配をうようよ感じてたらしい。
熊野水軍兵たちか、海面に上がってこれない自殺者たちか、定かではない。
またエレベーターで上に上がって、断崖から繋がってる千畳敷へ歩いていく途中
見たかった看板を発見★

思い詰めた人がコレ見て思いとどまれるのかどうか、定かではない。
城ヶ島みたいだな。

ココに飛び込む勇気はないな。

黒潮を堪能した後は、土産屋を回って、本日の宿へ。
台風被害で話題の田辺町のココ。

海側は被害が全く分からないから、ひどいのは山だけなんだろうな。
12Fの洋室。

テラスに椅子を出して、ナギサビールを飲みながら
見渡す限りの海をのんびり眺める。

太陽の黒点(?)が撮れたよ。

夕焼けを見て、買い込んだビールも尽きた頃

海を見ながらの露天風呂を堪能し(人がいたから写真撮れず)
お待ちかねの夕飯「熊野彩り御膳」なり。
春慶箱盛り上段:胡桃豆腐
菊葉みじん揚げ
玉子かすてら
むかご酒盗バター煎り
子持ち鮎昆布巻
寄せ馬鈴薯うに焼き

春慶箱盛り下段:秋鮭柚庵焼き
長芋とんぶりみそ掛け
紀州うめ鶏桑焼き
海老木の葉揚げ

向附:紀州鮮魚

蓋物:里芋豊年饅頭

食事:かつおご飯

追加料理:クエの煮付け

小鍋:紀州うめ豚のきのくに赤味噌仕立て

水菓子:柿、パンナコッタ、梨

デフォルトのコースだけでも満腹だったが
やっぱりクエを食え!ってことで頼んだクエの煮付け、絶品でございました。
銀ダラ煮付けのもっとまろやかな感じ。
台風直後だし、漁もままならないだろうに
昼抜きだったせいもあって(DLYのせいだ)、バクバクがっつくうちらに
店の人も「ちょっと厨房にあるかどうか聞いてきます」と
クエを無理矢理出してくれた感ww
紀州うめ鶏も、梅味だったらどうしようとビクビクしてたけど
紀州の梅酢を混ぜたえさで鶏を育てているだけらしく
大ッキライな梅の味は全くしなくて、一安心。
他のディッシュも梅味はなかったし、本とにヨカッタ。
モッキンは梅ワインとかガブガブ飲んでたけれども。
夜、もう1回お風呂入って、シャクシャクする不思議なアイスを食べ

テラス飲みして、初紀州の夜が更ける。

南紀白浜はとにかく宿が高くって、ご飯付きだと法外な値段になってしまう。
ココは1泊2食でリーズナブルってことで選んだんだけど
部屋も風呂も食事もサイコーのグレードだったな。
昨日の台風で午後の羽田発着便がほとんど欠航になったため
今日の便は余裕のヨシオだったはずなのに、全便満席に。
とりあえず昨日のうちに念のため特割で買っといてよかったが
余計な出費だ。今は考えないでおこう。
機材繰りの影響もあり、遅延で20分ほど待たされたところで
いきなりのバスラウンジへ搭乗口変更。
エンジンオイルが漏れてたらしく、機材も変更。
はーーー。とぼとぼ歩いてバスラウンジへ行き
「搭乗券で1000円分の買い物が出来まーす」というので
殺到した売店に並び、「ことりっぷ」をタダ買い。
結局1時間ほど遅れて出発。
初の関空に降り立った。
伊勢丹紙袋みたいな服を着てるお笑いの人に激似な、腰低過ぎな人と
舌が短すぎて何しゃべってるのか不明なおっさんがいるレンタカー屋で車を借り
いざ、聖地紀州へ。
東京は台風一過で蒸し暑かったけど、こっちは涼しい。
1時間半ほどで、白浜は三段壁へ。
和歌山出身の香里奈似の歯医者受付のおねいちゃんイチオシの
観光スポットならぬ自殺スポットだ。
海の色がミドリー!
中国訛りのおねいちゃんが案内するエレベーターで
地下36mの海蝕洞窟の内部に降り立つ。
熊野水軍が船を隠していたというこの洞窟で見れたザッパーーン!
干潮だとこんな迫力はないんだろう。
いつも干潮で鳥居のとこまで歩けてしまう宮島しか見たことないオレさまにとっては
今日は幸運であった。
ココから船で出撃してたのかー。
似合っちゃうなー水軍が。
そいへば、洞窟内で1枚だけ大量のオーブが撮れた。
もちろんこの前後も同じアングルなのに、クリアに撮れてる。
後から、この辺でモッキンが人の気配をうようよ感じてたらしい。
熊野水軍兵たちか、海面に上がってこれない自殺者たちか、定かではない。
またエレベーターで上に上がって、断崖から繋がってる千畳敷へ歩いていく途中
見たかった看板を発見★
思い詰めた人がコレ見て思いとどまれるのかどうか、定かではない。
城ヶ島みたいだな。
ココに飛び込む勇気はないな。
黒潮を堪能した後は、土産屋を回って、本日の宿へ。
台風被害で話題の田辺町のココ。
海側は被害が全く分からないから、ひどいのは山だけなんだろうな。
12Fの洋室。
テラスに椅子を出して、ナギサビールを飲みながら
見渡す限りの海をのんびり眺める。
太陽の黒点(?)が撮れたよ。
夕焼けを見て、買い込んだビールも尽きた頃
海を見ながらの露天風呂を堪能し(人がいたから写真撮れず)
お待ちかねの夕飯「熊野彩り御膳」なり。
春慶箱盛り上段:胡桃豆腐
菊葉みじん揚げ
玉子かすてら
むかご酒盗バター煎り
子持ち鮎昆布巻
寄せ馬鈴薯うに焼き
春慶箱盛り下段:秋鮭柚庵焼き
長芋とんぶりみそ掛け
紀州うめ鶏桑焼き
海老木の葉揚げ
向附:紀州鮮魚
蓋物:里芋豊年饅頭
食事:かつおご飯
追加料理:クエの煮付け
小鍋:紀州うめ豚のきのくに赤味噌仕立て
水菓子:柿、パンナコッタ、梨
デフォルトのコースだけでも満腹だったが
やっぱりクエを食え!ってことで頼んだクエの煮付け、絶品でございました。
銀ダラ煮付けのもっとまろやかな感じ。
台風直後だし、漁もままならないだろうに
昼抜きだったせいもあって(DLYのせいだ)、バクバクがっつくうちらに
店の人も「ちょっと厨房にあるかどうか聞いてきます」と
クエを無理矢理出してくれた感ww
紀州うめ鶏も、梅味だったらどうしようとビクビクしてたけど
紀州の梅酢を混ぜたえさで鶏を育てているだけらしく
大ッキライな梅の味は全くしなくて、一安心。
他のディッシュも梅味はなかったし、本とにヨカッタ。
モッキンは梅ワインとかガブガブ飲んでたけれども。
夜、もう1回お風呂入って、シャクシャクする不思議なアイスを食べ
テラス飲みして、初紀州の夜が更ける。
南紀白浜はとにかく宿が高くって、ご飯付きだと法外な値段になってしまう。
ココは1泊2食でリーズナブルってことで選んだんだけど
部屋も風呂も食事もサイコーのグレードだったな。
台風のフー子。
台風来るのは知ってましたさ。
でも、15時に「あと2時間で駅がクローズされるので、帰りたい人は早退してください」
と書かれたボードを、新人ちゃんがラウンドガールのように見せ歩いてたのには
ちょっとビックラ。
あたふたと皆さん帰って行く中、デターー。
「特殊部署は帰っちゃダメ」と。
は???うちらは帰れなくなってもいーわけ?
こんな時ばっかり特殊扱いしやがって。
「タクシーチケット出すから」っつうけど、タクシー捕まるわけねーぢゃん。
もし、KYババアが今日の責任者だったらとっとと無視して帰ってたけど
今日に限って、頑張ってくれてる人が責任者・・・。
みんな不安に駆られながらも仕事をこなし
いざ終業時間になっても、タクシーチケットのタの字もない。
むっかついて、次長に「タクシーチケットくれ!!」と言いに行ったら
言ったベースで切ってくれたけど、知らない人はもらえてない。
相変わらず危機管理がなってないにもほどがある。
どっちにしても電車全部止まってるから、たんたんと休憩室でしばらくTV見て
「どーすんべー」と言ってたら、19:30頃山手線が動き始めたとの朗報。
速攻駅に行ってみたが、すんごい人の波で改札まで辿り着けない。
改札に入るのも、そのまた後のホームへのエスカレーターも規制していた。

あきらめて、看板とか窓ガラスとかがビュービュー飛んでる爆風の中
隣の駅まで歩いてみた。幸い雨は止んでる。
何とか隣駅まで辿り着き、意外に改札もスイスイ入れて
山手線も動いていたので、大喜びでダッシュ乗りしたらアータ
着いた次の駅は、うちの職場駅だったとゆー。
スタートに戻る・・・orz
何やってんだオレら!
地縛霊の修行って、きっとこんなんだろう。
いつまでたっても進めないのだ。
改札の外はまだ規制してたけど、唯一穴を見つけて
反対方面ホームに駆け降り、ギュウギュウ詰めの電車に無理矢理乗る。
すんずくに着いたら、小田急や京王はずーっと止まったまんまらしく
西口が通れないほど人でいっぱいだった。
この人たちはまだまだ待つんだろう。
夕方から待ってる人もいるんだろう。
みんな疲れるね。
バスは動いていたので、何とか帰宅。
こういう緊急時にお決まりのワタミでごはん。

明日からの旅がヤバイことになりそうだ。
でも、15時に「あと2時間で駅がクローズされるので、帰りたい人は早退してください」
と書かれたボードを、新人ちゃんがラウンドガールのように見せ歩いてたのには
ちょっとビックラ。
あたふたと皆さん帰って行く中、デターー。
「特殊部署は帰っちゃダメ」と。
は???うちらは帰れなくなってもいーわけ?
こんな時ばっかり特殊扱いしやがって。
「タクシーチケット出すから」っつうけど、タクシー捕まるわけねーぢゃん。
もし、KYババアが今日の責任者だったらとっとと無視して帰ってたけど
今日に限って、頑張ってくれてる人が責任者・・・。
みんな不安に駆られながらも仕事をこなし
いざ終業時間になっても、タクシーチケットのタの字もない。
むっかついて、次長に「タクシーチケットくれ!!」と言いに行ったら
言ったベースで切ってくれたけど、知らない人はもらえてない。
相変わらず危機管理がなってないにもほどがある。
どっちにしても電車全部止まってるから、たんたんと休憩室でしばらくTV見て
「どーすんべー」と言ってたら、19:30頃山手線が動き始めたとの朗報。
速攻駅に行ってみたが、すんごい人の波で改札まで辿り着けない。
改札に入るのも、そのまた後のホームへのエスカレーターも規制していた。
あきらめて、看板とか窓ガラスとかがビュービュー飛んでる爆風の中
隣の駅まで歩いてみた。幸い雨は止んでる。
何とか隣駅まで辿り着き、意外に改札もスイスイ入れて
山手線も動いていたので、大喜びでダッシュ乗りしたらアータ
着いた次の駅は、うちの職場駅だったとゆー。
スタートに戻る・・・orz
何やってんだオレら!
地縛霊の修行って、きっとこんなんだろう。
いつまでたっても進めないのだ。
改札の外はまだ規制してたけど、唯一穴を見つけて
反対方面ホームに駆け降り、ギュウギュウ詰めの電車に無理矢理乗る。
すんずくに着いたら、小田急や京王はずーっと止まったまんまらしく
西口が通れないほど人でいっぱいだった。
この人たちはまだまだ待つんだろう。
夕方から待ってる人もいるんだろう。
みんな疲れるね。
バスは動いていたので、何とか帰宅。
こういう緊急時にお決まりのワタミでごはん。
明日からの旅がヤバイことになりそうだ。
良心があと4人になってしまいました。
職場Our部署のデスク。
広く見えるが、当部署の一角はすげー狭く、蔑まされている。

下部に見えたるクマのクッキー箱は
こないだ国盗りに九州新幹線に乗ってきたたんたんの熊本土産。
くまモンとゆーキャラで、一時大ブームに。
本日は、またOur部署の良心の1人:Mコッチがラストの日。

「何色が好き?」と聞いたら「緑!」と答えたので
みんなで緑色の花をうんうん考えたのだが、コケだの木だのしか思い浮かばず
オレさまが「アスパラとか小松菜とかの野菜をブーケっぽくしようよ!」と
近年稀に見るナイスアイディアを出したのだが
ベラボーに野菜が高い昨今(白菜1個600円ですわよ奥様!)
速攻却下となり、他に好きな色を聞いたところ
この花束に落ち着きました。
ラスト時間間際には、やはり撮影大会となり

「お前のせいで辞めるのに、何故お前が全てに写っている(怒)!!」な
KYまっしぐらなババアが、本当に全ての写真にしゃしゃり出ていて
Mコッチも嫌そうな顔・・・。
周りで見てた人たちも失笑だったそうな。
本気でバカかおまいわ!!!あー腹立つ!!
Our部署をメチャクチャにぶっ壊しやがって
呼んでもないのに、何で出てくんだよっ!!
オレさまが辞める時に、もしイソイソと出しゃばってきたら
「アナタはいいです」と言ってやろー絶対に。
Mコッチからもらったクルミッ子。

初めて食べたけど、鎌倉名物だそうだ。
めちゃ美味しくてビックリ!
あーOur部署が崩壊していく。
解散も時間の問題だ。
広く見えるが、当部署の一角はすげー狭く、蔑まされている。
下部に見えたるクマのクッキー箱は
こないだ国盗りに九州新幹線に乗ってきたたんたんの熊本土産。
くまモンとゆーキャラで、一時大ブームに。
本日は、またOur部署の良心の1人:Mコッチがラストの日。
「何色が好き?」と聞いたら「緑!」と答えたので
みんなで緑色の花をうんうん考えたのだが、コケだの木だのしか思い浮かばず
オレさまが「アスパラとか小松菜とかの野菜をブーケっぽくしようよ!」と
近年稀に見るナイスアイディアを出したのだが
ベラボーに野菜が高い昨今(白菜1個600円ですわよ奥様!)
速攻却下となり、他に好きな色を聞いたところ
この花束に落ち着きました。
ラスト時間間際には、やはり撮影大会となり
「お前のせいで辞めるのに、何故お前が全てに写っている(怒)!!」な
KYまっしぐらなババアが、本当に全ての写真にしゃしゃり出ていて
Mコッチも嫌そうな顔・・・。
周りで見てた人たちも失笑だったそうな。
本気でバカかおまいわ!!!あー腹立つ!!
Our部署をメチャクチャにぶっ壊しやがって
呼んでもないのに、何で出てくんだよっ!!
オレさまが辞める時に、もしイソイソと出しゃばってきたら
「アナタはいいです」と言ってやろー絶対に。
Mコッチからもらったクルミッ子。
初めて食べたけど、鎌倉名物だそうだ。
めちゃ美味しくてビックリ!
あーOur部署が崩壊していく。
解散も時間の問題だ。
こよみ
| 01 | 2026/02 | 03 |
| S | M | T | W | T | F | S |
|---|---|---|---|---|---|---|
| 1 | 2 | 3 | 4 | 5 | 6 | 7 |
| 8 | 9 | 10 | 11 | 12 | 13 | 14 |
| 15 | 16 | 17 | 18 | 19 | 20 | 21 |
| 22 | 23 | 24 | 25 | 26 | 27 | 28 |
おじかん
新しいご意見
[08/06 Odopsdusdot]
[08/05 Odopsdusdot]
[08/02 Arensenut]
[08/02 BisyBiodayCip]
[08/01 gakyemantee]
[07/30 annohisminync]
新しいにっき
(04/20)
(04/19)
(01/20)
(01/19)
(01/18)
(10/15)
(10/14)
(10/13)
(09/12)
(09/11)
おれおれ
HN:
う。の者
性別:
非公開


